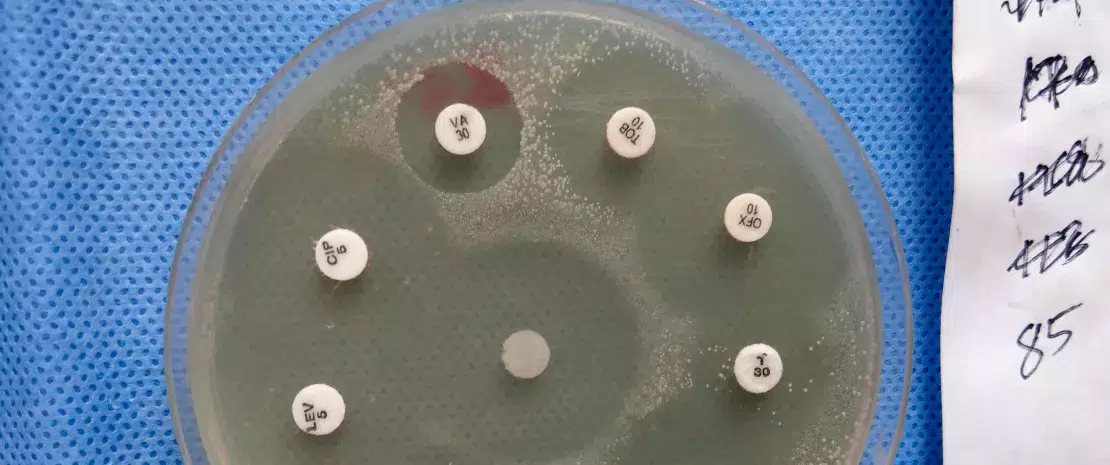
Do antibiotics make gut microbiota less resilient?

Могут ли антибиотики влиять на резистентность микробиоты кишечника?
Даже у здоровых людей короткие курсы антибиотиков часто приводят к нарушению микробиоты кишечника. Такое лечение может иметь последствия, в ближайшее время и отдаленно, включая устойчивость к антибиотикам.
Раздел для широкой публики
Найдите здесь свое выделенное место
en_sources_title
en_sources_text_start en_sources_text_end
Делиться - значит заботиться
Возможно, эта тема заинтересует ваших коллег. Почему бы не поделиться ею?
Об этой статье
Медицинские исследования антибиотиков ограничены тем, что обычно они проходят с участием госпитализированных пациентов, получающих многочисленные лекарственные препараты. Существует множество вмешивающихся факторов (инфекции, лекарственные препараты, больничная среда, потенциальная иммуносупрессия), искажающих результаты исследований.
Единственным решением является проведение проспективных исследований с участием здоровых взрослых добровольцев вне больничных условий. Так, группа американских ученых изучила влияние четырех антибиотиков, в том числе, азитромицина (AZM), левофлоксацина (LVX), цефподоксима (CPD) и комбинации CPD и AZM, на микробиоту кишечника 20 здоровых добровольцев, которые были рандомизированы и включены в четыре группы, анализ образцов кала проводили до, во время и через два месяца после окончания применения антибиотиков (всего 15 процедур взятия образцов у каждого участника).
Дисбиоз кишечника, вызванный применением антибиотиков
Первый вывод: антибиотики уменьшают содержание бактерий и их разнообразие. Изменения численности бактерий зависели от получаемого антибиотика.
- Так, на шестой день получения CPD или CPD + AZM у участников отмечалось более высокое содержание Bacteroidetes и Clostridium,
- тогда как LVX или AZM ассоциировались с преобладанием Firmicutes, таких как Eubacterium, Ruminococcus и Anaerostipes.
Кроме того, AZM (отдельно или в комбинации), который имеет длительный период полувыведения, задерживал восстановление содержания восьми видов бактерий и некоторых связанных с ними метаболических путей по сравнению с другими антибиотиками.
Резервуар генов резистентности
Другим эффектом антибиотиков было появление долговременного резервуара генов резистентности у добровольцев, получавших CPD, AZM и CPD + AZM, в отличие от тех, кто получал LVX. Однако, что более важно, измененный состав их резистома приводил к увеличению содержания трех генов (tetO, cfxA и tet40), два из которых не придают устойчивости к применяемым антибиотикам. Следовательно, нарушения микрофлоры, связанные с применением антибиотиков, могут создавать благоприятные условия для роста бактерий с широкой устойчивостью. Например, Bacteroides, которые выживают после лечения CPD, вероятно, с помощью гена резистентности к ß-лактамазам cfxA могут создавать среду с низким разнообразием и высоким содержанием Bacteroides, что способствует росту патогенов, таких как Enterobacter. Даже короткие курсы антибиотиков могут привести к приобретению или закреплению различных генов резистентности.
Стойкость микробиоты варьируется от человека к человеку
У 17 из 20 добровольцев дисбиоз, вызванный антибиотиками, был лишь умеренным и преходящим, причем микробиота вернулась к своему прежнему состоянию за несколько недель. Наоборот, у трех других участников с изначально низким разнообразием микробиоты кишечника применение антибиотиков вызвало более выраженный дисбиоз (почти такой же, как у пациентов из отделений интенсивной терапии), в части случаев сохранявшийся в конце периода наблюдения, то есть через 2 месяца после завершения лечения. Все это указывает на необходимость разумного применения антибиотиков.